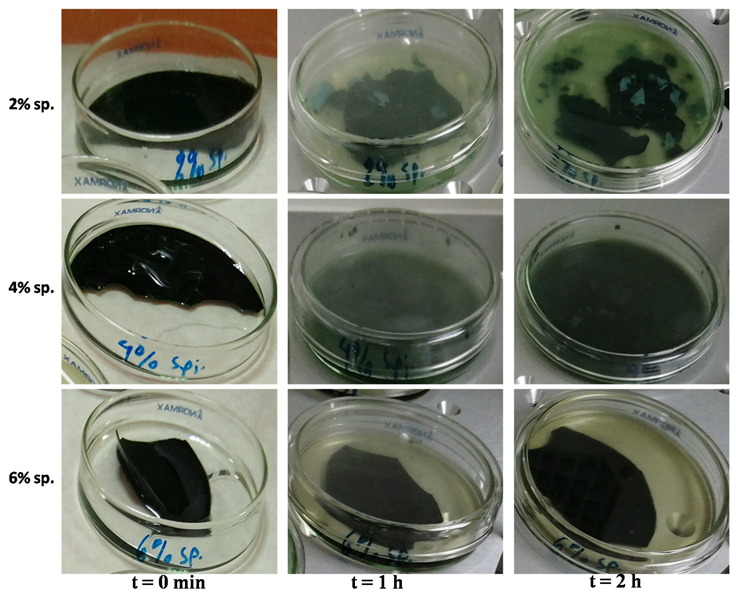
Sustainability 15 13909 g002

Innovative Intelligent Cheese Packaging with Whey Protein-Based Edible Films Containing Spirulina
Abstract
:1. Introduction
2. Materials and Methods
2.1. Chemicals and Standards
2.2. Preparation of Film Systems
2.3. Color Measurements
2.4. Total Phenolic Content
2.5. Viability of Films in Simulated Gastric Juice and Intelligent Material Analysis
2.6. Application as Packaging for “kefalotyri” Cheese Pieces
2.7. Microbiological Analyses
2.8. Analysis of Volatile Compounds: Identification and Percentage Ratio of Volatile Compounds Using SPME–GC/MS
2.9. NIR Spectroscopy: Spectra Acquisition
2.10. Statistical Analysis
3. Results
3.1. Color Measurements
3.2. Total Phenolic Content
3.3. Simulated Gastric Juice Test and Intelligent Material Analysis
3.4. Evaluation of Films as Packaging Material of “kefalotyri” Cheese Pieces
3.5. Microbiological Changes of “kefalotyri” Cheese with Edible Films Applied
3.6. Analysis of Volatile Compounds of Films, sp. Powde r, etc.
3.7. NIR Spectroscopy: Chemical Composition of “kefalotyri” Cheese Sample with Film
4. Conclusions
Supplementary Materials
Author Contributions
Funding
Institutional Review Board Statement
Informed Consent Statement
Data Availability Statement
Conflicts of Interest
References
- Ali, A.M.M.; Sant’Ana, A.S.; Bavisetty, S.C.B. Sustainable preservation of cheese: Advanced technologies, physicochemical properties and sensory attributes. Trends Food Sci. Technol. 2022, 129, 306–326. [Google Scholar] [CrossRef]
- Rodríguez-Félix, F.; Corte-Tarazón, J.A.; Rochín-Wong, S.; Fernández-Quiroz, J.D.; Garzón-García, A.M.; Santos-Sauceda, I.; Plascencia-Martínez, D.F.; Chan-Chan, L.H.; Vásquez-López, C.; Barreras-Urbina, C.G.; et al. Physicochemical, structural, mechanical and antioxidant properties of zein films incorporated with no-ultrafiltered and ultrafiltered betalains extract from the beetroot (Beta vulgaris) bagasse with potential application as active food packaging. J. Food Eng. 2022, 334, 111153. [Google Scholar] [CrossRef]
- Jafarzadeh, S.; Salehabadi, A.; Nafchi, A.M.; Oladzadabbasabadi, N.; Jafari, S.M. Cheese packaging by edible coatings and biodegradable nanocomposites; improvement in shelf life, physicochemical and sensory properties. Trends Food Sci. Technol. 2021, 116, 218–231. [Google Scholar] [CrossRef]
- Costa, M.J.; Maciel, L.C.; Teixeira, J.A.; Vicente, A.A.; Cerqueira, M.A. Use of edible films and coatings in cheese preservation: Opportunities and challenges. Food Res. Int. 2018, 107, 84–92. [Google Scholar] [CrossRef] [PubMed]
- De Castro, R.J.S.; Domingues, M.A.F.; Ohara, A.; Okuro, P.K.; dos Santos, J.G.; Brexó, R.P.; Sato, H.H. Whey protein as a key component in food systems: Physicochemical properties, production technologies and applications. Food Struct. 2017, 14, 17–29. [Google Scholar] [CrossRef]
- Daniloski, D.; Petkoska, A.T.; Lee, N.A.; Bekhit, A.E.-D.; Carne, A.; Vaskoska, R.; Vasiljevic, T. Active edible packaging based on milk proteins: A route to carry and deliver nutraceuticals. Trends Food Sci. Technol. 2021, 111, 688–705. [Google Scholar] [CrossRef]
- Mellinas, C.; Valdés, A.; Ramos, M.; Burgos, N.; Del Carmen Garrigós, M.; Jiménez, A. Active edible films: Current state and future trends. J. Appl. Polym. Sci. 2016, 133, 42631. [Google Scholar] [CrossRef]
- Karača, S.; Trifković, K.; Martinić, A.; Đorđević, V.; Šeremet, D.; Cebin, A.V.; Bugarski, B.; Komes, D. Development and characterisation of functional cocoa (Theobroma cacao L.)-based edible films. Int. J. Food Sci. Technol. 2020, 55, 1326–1335. [Google Scholar] [CrossRef]
- Ma, Y.; Yang, W.; Xia, Y.; Xue, W.; Wu, H.; Li, Z.; Zhang, F.; Qiu, B.; Fu, C. Properties and Applications of Intelligent Packaging Indicators for Food Spoilage. Membranes 2022, 12, 477. [Google Scholar] [CrossRef]
- Pluta-Kubica, A.; Jamróz, E.; Kawecka, A.; Juszczak, L.; Krzyściak, P. Active edible furcellaran/whey protein films with yerba mate and white tea extracts: Preparation, characterization and its application to fresh soft rennet-curd cheese. Int. J. Biol. Macromol. 2020, 155, 1307–1316. [Google Scholar] [CrossRef]
- Robalo, J.; Lopes, M.; Cardoso, O.; Silva, A.S.; Ramos, F. Efficacy of Whey Protein Film Incorporated with Portuguese Green Tea (Camellia sinensis L.) Extract for the Preservation of Latin-Style Fresh Cheese. Foods 2022, 11, 1158. [Google Scholar] [CrossRef] [PubMed]
- Kontogianni, V.G.; Kasapidou, E.; Mitlianga, P.; Mataragas, M.; Pappa, E.; Kondyli, E.; Bosnea, L. Production, characteristics and application of whey protein films activated with rosemary and sage extract in preserving soft cheese. Lwt 2022, 155, 112996. [Google Scholar] [CrossRef]
- Spolaore, P.; Joannis-Cassan, C.; Duran, E.; Isambert, A. Commercial applications of microalgae. J. Biosci. Bioeng. 2006, 101, 87–96. [Google Scholar] [CrossRef] [PubMed]
- Beheshtipour, H.; Mortazavian, A.M.; Mohammadi, R.; Sohrabvandi, S.; Khosravi-Darani, K. Supplementation of Spirulina platensis and Chlorella vulgaris Algae into Probiotic Fermented Milks. Compr. Rev. Food Sci. Food Saf. 2013, 12, 144–154. [Google Scholar] [CrossRef]
- Wells, M.L.; Potin, P.; Craigie, J.S.; Raven, J.A.; Merchant, S.S.; Helliwell, K.E.; Smith, A.G.; Camire, M.E.; Brawley, S.H. Algae as nutritional and functional food sources: Revisiting our understanding. J. Appl. Phycol. 2017, 29, 949–982. [Google Scholar] [CrossRef]
- Nakamoto, M.M.; Assis, M.; de Oliveira Filho, J.G.; Braga, A.R.C. Spirulina application in food packaging: Gaps of knowledge and future trends. Trends Food Sci. Technol. 2023, 133, 138–147. [Google Scholar] [CrossRef]
- Kontogianni, V.G.; Chatzikonstantinou, A.V.; Mataragas, M.; Kondyli, E.; Stamatis, H.; Bosnea, L. Evaluation of the Antioxidant and Physicochemical Properties of Microalgae/Whey Protein-Based Edible Films. Biol. Life Sci. Forum 2021, 6, 97. [Google Scholar] [CrossRef]
- Jamróz, E.; Kulawik, P.; Krzyściak, P.; Talaga-Ćwiertnia, K.; Juszczak, L. Intelligent and active furcellaran-gelatin films containing green or pu-erh tea extracts: Characterization, antioxidant and antimicrobial potential. Int. J. Biol. Macromol. 2019, 122, 745–757. [Google Scholar] [CrossRef]
- Cruz-Diaz, K.; Cobos, Á.; Fernández-Valle, M.E.; Díaz, O.; Cambero, M.I. Characterization of edible films from whey proteins treated with heat, ultrasounds and/or transglutaminase. Application in cheese slices packaging. Food Packag. Shelf Life 2019, 22, 100397. [Google Scholar] [CrossRef]
- Vatavali, K.; Kosma, I.; Louppis, A.; Gatzias, I.; Badeka, A.V.; Kontominas, M.G. Characterisation and differentiation of geographical origin of Graviera cheeses produced in Greece based on physico-chemical, chromatographic and spectroscopic analyses, in combination with chemometrics. Int. Dairy J. 2020, 110, 104799. [Google Scholar] [CrossRef]
- Özogul, I.; Kuley, E.; Durmus, M.; Özogul, Y.; Polat, A. The effects of microalgae (Spirulina platensis and Chlorella vulgaris) extracts on the quality of vacuum packaged sardine during chilled storage. J. Food Meas. Charact. 2021, 15, 1327–1340. [Google Scholar] [CrossRef]
- NIST05 National Institute of Standards and Technology. Mass Spectral Library; Wiley: West Sussex, UK, 2005. [Google Scholar]
- SPSS. IBM SPSS Statistics for Windows, Version 23.0 (Computer Software); IBM Corp.: Armonk, NY, USA, 2014. [Google Scholar]
- Balti, R.; Ben Mansour, M.; Sayari, N.; Yacoubi, L.; Rabaoui, L.; Brodu, N.; Massé, A. Development and characterization of bioactive edible films from spider crab (Maja crispata) chitosan incorporated with Spirulina extract. Int. J. Biol. Macromol. 2017, 105, 1464–1472. [Google Scholar] [CrossRef] [PubMed]
- Miranda, M.S.; Cintra, R.G.; Barros, S.B.M.; Mancini-Filho, J. Antioxidant activity of the microalga Spirulina maxima. Braz. J. Med. Biol. Res. 1998, 31, 1075–1079. [Google Scholar] [CrossRef] [PubMed]
- Nourmohammadi, N.; Soleimanian-Zad, S.; Shekarchizadeh, H. Effect of Spirulina (Arthrospira platensis) microencapsulated in alginate and whey protein concentrate addition on physicochemical and organoleptic properties of functional stirred yogurt. J. Sci. Food Agric. 2020, 100, 5260–5268. [Google Scholar] [CrossRef]
- Mishra, P.; Singh, V.P.; Mohan, S. Spirulina and its Nutritional Importance: A Possible Approach for Development of Functional Food. Biochem. Pharmacol. Open Access 2014, 3, 1000e171. [Google Scholar] [CrossRef]
- Terra, A.L.M.; Moreira, J.B.; Costa, J.A.V.; de Morais, M.G. Development of pH indicators from nanofibers containing microalgal pigment for monitoring of food quality. Food Biosci. 2021, 44, 101387. [Google Scholar] [CrossRef]
- Kuntzler, S.G.; Costa, J.A.V.; Brizio, A.P.D.R.; de Morais, M.G. Development of a colorimetric pH indicator using nanofibers containing Spirulina sp. LEB 18. Food Chem. 2020, 328, 126768. [Google Scholar] [CrossRef]
- Chaudhary, V.; Kajla, P.; Kumari, P.; Bangar, S.P.; Rusu, A.; Trif, M.; Lorenzo, J.M. Milk protein-based active edible packaging for food applications: An eco-friendly approach. Front. Nutr. 2022, 9, 942524. [Google Scholar] [CrossRef]
- FDA GRAS Notification: “Spirulina” microalgae. Available online: https://www.algbiotek.com/spirulina-sertifikalar/Spirulina-GRAS-grn_101.pdf (accessed on 2 September 2023).
- Stejskal, N.; Miranda, J.M.; Martucci, J.F.; Ruseckaite, R.A.; Barros-Velázquez, J.; Aubourg, S.P. Quality Enhancement of Refrigerated Hake Muscle by Active Packaging with a Protein Concentrate from Spirulina platensis. Food Bioprocess Technol. 2020, 13, 1110–1118. [Google Scholar] [CrossRef]
- Chentir, I.; Hamdi, M.; Li, S.; Doumandji, A.; Markou, G.; Nasri, M. Stability, bio-functionality and bio-activity of crude phycocyanin from a two-phase cultured Saharian Arthrospira sp. strain. Algal Res. 2018, 35, 395–406. [Google Scholar] [CrossRef]
- Stejskal, N.; Miranda, J.M.; Martucci, J.F.; Ruseckaite, R.A.; Aubourg, S.P.; Barros-Velázquez, J. The Effect of Gelatine Packaging Film Containing a Spirulina platensis Protein Concentrate on Atlantic Mackerel Shelf Life. Molecules 2020, 25, 3209. [Google Scholar] [CrossRef] [PubMed]
- Martelli, F.; Cirlini, M.; Lazzi, C.; Neviani, E.; Bernini, V. Edible Seaweeds and Spirulina Extracts for Food Application: In Vitro and In Situ Evaluation of Antimicrobial Activity towards Foodborne Pathogenic Bacteria. Foods 2020, 9, 1442. [Google Scholar] [CrossRef] [PubMed]
- Ozdemir, G.; Karabay, N.U.; Dalay, M.C.; Pazarbasi, B. Antibacterial activity of volatile component and various extracts ofSpirulina platensis. Phytother. Res. 2004, 18, 754–757. [Google Scholar] [CrossRef] [PubMed]

| Film | L * | A * | B * | TPC (mg Gallic/g Film) |
|---|---|---|---|---|
| Control | 75.17 ± 0.44 e,* | −3.36 ± 0.39 d | 15.91 ± 0.43 c | 62.00 ± 4.35 b |
| 0.5% sp. | 51.88 ± 0.29 d | −18.80 ± 1.44 b | 24.86 ± 0.45 e | 41.00 ± 2.22 a |
| 1% sp. | 29.99 ± 0.23 c | −21.57 ± 1.04 a | 21.73 ± 0.47 d | 86.75 ± 5.11 d |
| 2% sp. | 14.75 ± 0.29 b | −8.95 ± 0.66 c | 6.22 ± 0.44 b | 100.75 ± 6.21 e |
| 4% sp. | 7.08 ± 0.13 a | −0.90 ± 0.03 e | −0.27 ± 0.05 a | 74.75 ± 3.52 c |
| Kefalotyri log cfu/g | Kefalotyri + Film Control log cfu/g | Kefalotyri + Film spirulina log cfu/g | ||||
|---|---|---|---|---|---|---|
| Time (days) of Storage | TVC | Yeasts/Molds | TVC | Yeasts/Molds | TCV | Yeasts/Molds |
| 0 | 7.2 ± 0.0 a,* | 3.2 ± 1.1 A,** | 7.2 ± 0.1 b | 3.1 ± 0.0 A | 7.4 ± 0.1 b | 2.6 ± 0.5 A |
| 30 | 8.0 ± 0.1 b | 5.3 ± 1.6 A | 7.2 ± 0.1 a | 3.6 ± 1.9 A | 7.8 ± 0.3 b | 3.2 ± 1.4 A |
| 60 | 9.2 ± 1.0 b | 7.6 ± 1.3 B | 8.2 ± 0.4 b | 5.6 ± 1.0 B | 7.7 ± 0.1 a | 3.6 ± 0.2 A |
| Control (%) | 2% sp. (%) | ||||
|---|---|---|---|---|---|
| A/A | RI Exp * | RI Lit ** | Compound | ||
| 1 | 571 | 606 | Acetic acid | 18.1 | 11.55 |
| 2 | 690 | 695 | Pentanal | - | 0.16 |
| 3 | 780 | 785 | Disulfide, dimethyl | - | 0.03 |
| 4 | 790 | 784 | Butanoic acid | 0.43 | - |
| 5 | 793 | 810 | Hexanal | 3.29 | 3.31 |
| 6 | 848 | 854 | (E)- 2-hexenal, | - | 0.07 |
| 7 | 890 | Oxime-, methoxy-phenyl- | 0.33 | 0.27 | |
| 8 | 895 | 893 | Styrene; | 0.3 | 0.23 |
| 9 | 895 | 899 | n- heptanal | 0.39 | 0.34 |
| 10 | 925 | 915 | Pyrazine, 2,5-dimethyl- | 0.27 | 0.43 |
| 11 | 933 | 963 | 2(E)-heptenal | - | 0.88 |
| 12 | 955 | 970 | Hexanoic acid | 2.04 | 2.84 |
| 13 | 989 | Glycerin | 44.21 | 33.25 | |
| 14 | 1067 | 1083 | Heptanoic acid | - | 0.74 |
| 15 | 1067 | 1062 | 2 octenal | 0.41 | 1 |
| 16 | 1070 | 1070 | 1-octanol | - | 0.36 |
| 17 | 1100 | 1099 | Nonanal | 3.84 | 2.96 |
| 18 | 1110 | 1088 | Maltol | 0.62 | 0.4 |
| 19 | 1110 | 1110 | Cyclohexanol, 2,6-dimethyl- | - | 0.75 |
| 20 | 1184 | 1193 | Octanoic acid | 5.83 | 6.35 |
| 21 | 1200 | 9H-pyrrolo[3’,4’:3,4]pyrrolo[2,1-a]phthalazine-9,11(10H)-dione,10-ethyl-8-phenyl | - | 0.1 | |
| 22 | 1210 | 1203 | Decanal | 0.57 | 0.37 |
| 23 | 1218 | 1198 | 1,3-cyclohexadiene-1-carboxaldehyde, 2,6,6-trimethyl- | - | 0.13 |
| 24 | 1230 | 1280 | 1H-pyrrole-2,5-dione, 3-ethyl-4-methyl- | 0.18 | 0.78 |
| 25 | 1233 | 1208 | 1-cyclohexene-1-carboxaldehyde, 2,6,6-trimethyl- | - | 0.13 |
| 26 | 1238 | 1237 | Nonanoic acid | 8.92 | 11.51 |
| 27 | 1289 | 1300 | Tridecane | 0.22 | 0.14 |
| 28 | 1356 | 1371 | Decanoic acid | 3.01 | 2.12 |
| 29 | 1405 | 1400 | Tetradecane | 0.15 | 0.13 |
| 30 | 1425 | 1617 | Tetradecanal | 1.35 | 0.94 |
| 31 | 1475 | 1437 | alpha-ionone | - | 0.08 |
| 32 | 1485 | 1454 | (E)-geranylacetone | 0.32 | 0.24 |
| 33 | 1493 | 1478 | 2,6-di(t-butyl)-4-hydroxy-4-methyl-2,5-cyclohexadien-1-one | 0.06 | - |
| 34 | 1498 | Cyclododecane | 0.38 | 0.18 | |
| 35 | 1501 | 4,5,6,7-tetrahydro-7,7-dimethyl-1(3H)-isobenzofuranone | - | 0.08 | |
| 36 | 1510 | 1493 | .beta.-Ionone | 0.85 | 2.23 |
| 37 | 1515 | beta.-Ionone epoxide | - | 0.73 | |
| 38 | 1585 | 1538 | (2,6,6-trimethyl-2-hydroxycyclohexylidene)acetic acid lactone | 0.43 | 1.54 |
| 39 | 1595 | 1600 | Hexadecane | 0.48 | 0.95 |
| 40 | 1620 | 1811 | Hexadecanal | 0.26 | 0.15 |
| 41 | 1685 | 1648 | Methyl dihydrojasmonate | 0.16 | 0.11 |
| 42 | 1691 | 1668 | 6(Z),9(E)-heptadecadiene | - | 0.04 |
| 43 | 1694 | 1694 | 1-heptadecene | 0.1 | 0.19 |
| 44 | 1695 | 1659 | 4-oxo-beta-ionone | - | 0.05 |
| 45 | 1699 | 1700 | Heptadecane | 2.51 | 11.15 |
| sp. Powder (%) | ||||
|---|---|---|---|---|
| A/A | RI Exp * | RI Lit ** | Compound | |
| 1 | <500 | <500 | Acetaldehyde | 0.30 |
| 2 | <500 | <500 | 2-propanone | 0.26 |
| 3 | 569 | 606 | Acetic acid | 0.02 |
| 4 | 610 | 605 | Furan, 2-methyl- | 0.02 |
| 5 | 656 | 650 | Butanal, 3-methyl- | 0.02 |
| 6 | 659 | 661 | 1-butanol | 0.02 |
| 7 | 690 | 695 | Pentanal | 0.07 |
| 8 | 735 | 736 | 1-butanol, 3-methyl- | 0.04 |
| 9 | 738 | 740 | 1-butanol, 2-methyl- | 0.05 |
| 10 | 750 | 766 | 1-pentanol | 0.40 |
| 11 | 785 | 798 | Hexanal | 0.87 |
| 12 | 809 | 827 | Pyrazine, methyl- | 0.21 |
| 13 | 825 | 920 | Formic acid, hexylester | 1.68 |
| 14 | 901 | 890 | Pyridine, 2,6-dimethyl- | 0.09 |
| 15 | 903 | 899 | 2-heptanone | 0.17 |
| 16 | 910 | 896 | 2-heptanol | 0.09 |
| 17 | 911 | 899 | n- heptanal | 0.16 |
| 18 | 928 | 915 | Pyrazine, 2,5-dimethyl- | 1.29 |
| 19 | 959 | 954 | 2-heptanone, 6-methyl- | 0.10 |
| 20 | 965 | 963 | (E)-2-heptenal, | 0.03 |
| 21 | 980 | 963 | Benzaldehyde | 0.33 |
| 22 | 981 | 983 | 1-octen-3-ol | 1.12 |
| 23 | 984 | 985 | 6-methyl-5-hepten-2-one | 0.40 |
| 24 | 987 | 992 | 2-Octanone | 0.12 |
| 25 | 987 | 998 | Furan, 2-pentyl- | 0.54 |
| 26 | 989 | 2-heptanol, 6-methyl- | 0.06 | |
| 27 | 990 | 1006 | Pyrazine, 2-ethyl-6-methyl- | 0.04 |
| 28 | 991 | 976 | Benzene, 1,3,5-trimethyl- | 0.03 |
| 29 | 1000 | 1192 | Phenol, 2-methoxy-4-methyl- | 0.03 |
| 30 | 1025 | 1035 | Benzenemethanol | 0.15 |
| 31 | 1030 | 1047 | Cyclohexanone, 2,2,6-trimethyl- | 0.59 |
| 32 | 1039 | 2,3,4,5-tetramethyl-2-cyclopenten-1-one B | 0.43 | |
| 33 | 1045 | 1054 | (Z)-2-octen-1-ol | 0.73 |
| 34 | 1047 | 1120 | 2-cyclohexen-1-one, 3,5,5-trimethyl- | 0.48 |
| 35 | 1075 | 1091 | Pyrazine, 3-ethyl-2,5-dimethyl- | 0.22 |
| 36 | 1079 | 1198 | 2-cyclohexen-1-one, 3,4,4-trimethyl- | 0.18 |
| 37 | 1085 | 1110 | 6-methyl-3,5-heptadien-2-one | 0.86 |
| 38 | 1091 | 1282 | Phenol, 5-methyl-2-(1-methylethyl)- | 0.08 |
| 39 | 1094 | 2-(t-butyl)-3-methylthiophene | 0.39 | |
| 40 | 1100 | 1110 | Cyclohexanol, 2,6-dimethyl- | 0.06 |
| 41 | 1115 | 1123 | 2-cyclohexene-1-carboxaldehyde, 2,6,6-trimethyl- | 0.18 |
| 42 | 1130 | 4(5)-acetyl-2-(2-propyl)-1H-imidazole | 2.96 | |
| 43 | 1201 | 1208 | Benzaldehyde, 2,5-dimethyl- | 0.34 |
| 44 | 12010 | 1200 | Dodecane | 0.39 |
| 45 | 1210 | 1139 | Ethanone, 1-(2-methylphenyl)- | 0.25 |
| 46 | 1215 | 1202 | Pyridine, 2-pentyl- | 0.49 |
| 47 | 1220 | 1213 | Undecane, 2,6-dimethyl- | 0.09 |
| 48 | 1225 | 1206 | 1,3-cyclohexadiene-1-carboxaldehyde, 2,6,6-trimethyl- | 0.77 |
| 49 | 1240 | 1280 | 1H-pyrrole-2,5-dione, 3-ethyl-4-methyl- | 0.53 |
| 50 | 1249 | 1226 | beta-cyclocitral | 0.89 |
| 51 | 1259 | Cyclododecane | 0.03 | |
| 52 | 1289 | 1275 | 4,8-dimethyl-nona-3,8-dien-2-one | 0.08 |
| 53 | 1290 | 1251 | 1-cyclohexene-1-acetaldehyde, 2,6,6-trimethyl- | 0.08 |
| 54 | 1299 | 3-cyano-2,4,4-trimethyl-2-cyclohexenone | 0.16 | |
| 55 | 1301 | 1300 | Tridecane | 0.17 |
| 56 | 1303 | 2-cyclopenten-1-one, 2-pentyl- | 0.30 | |
| 57 | 1310 | 2-butyl-3-methylpyrazine | 0.14 | |
| 58 | 1325 | m-cresol, 6-tert-butyl- | 0.07 | |
| 59 | 1390 | 1355 | 2-octenal, 2-butyl- | 0.17 |
| 60 | 1394 | alpha-ionene | 0.27 | |
| 61 | 1401 | Thiosulfuric acid (H2S2O3), S-(2-aminoethyl) ester | 0.08 | |
| 62 | 1405 | 1400 | Tetradecane | 0.64 |
| 63 | 1440 | 1408 | 2-undecanone, 6,10-dimethyl- | 0.21 |
| 64 | 1452 | 1437 | alpha-ionone | 0.54 |
| 65 | 1465 | 5,9-undecadien-2-one, (E)-6,10-dimethyl-, | 0.6 | |
| 66 | 1476 | 1800 | Octadecane | 0.12 |
| 67 | 1481 | 4,5,6,7-tetrahydro-7,7-dimethyl-1(3H)-isobenzofuranone | 0.39 | |
| 68 | 1486 | 1587 | 1-hexadecene | 0.22 |
| 69 | 1492 | 1485 | 4-(2,6,6-trimethylcyclohexa-1,3-dienyl)but-3-en-2-one | 0.47 |
| 70 | 1495 | 1500 | Pentadecane | 14.27 |
| 71 | 1499 | beta-ionone epoxide | 5.10 | |
| 72 | 1569 | 1539 | 2(4H)-benzofuranone, 5,6,7,7a-tetrahydro-4,4,7a-trimethyl- | 3.46 |
| 73 | 1575 | (Z)-7-hexadecene | 0.28 | |
| 74 | 1581 | (E)-2-nonadecene | 0.05 | |
| 75 | 1592 | 1600 | Hexadecane | 9.04 |
| 76 | 1599 | 2000 | Eicosane | 0.02 |
| 77 | 1671 | 1668 | 6(Z),9(E)-heptadecadiene | 0.62 |
| 78 | 1679 | 1677 | 8-heptadecene | 2.88 |
| 79 | 1681 | (Z)-3-heptadecene | 0.2 | |
| 80 | 1692 | 1700 | Heptadecane | 39.32 |
| 81 | 1798 | 1800 | Octadecane | 0.15 |
| 82 | 1813 | 1846 | 2-pentadecanone, 6,10,14-trimethyl- | 0.17 |
| 83 | 1890 | 1900 | Nonadecane | 0.04 |
Disclaimer/Publisher’s Note: The statements, opinions and data contained in all publications are solely those of the individual author(s) and contributor(s) and not of MDPI and/or the editor(s). MDPI and/or the editor(s) disclaim responsibility for any injury to people or property resulting from any ideas, methods, instructions or products referred to in the content. |
© 2023 by the authors. Licensee MDPI, Basel, Switzerland. This article is an open access article distributed under the terms and conditions of the Creative Commons Attribution (CC BY) license (https://creativecommons.org/licenses/by/4.0/).
Share and Cite
Kontogianni, V.G.; Kosma, I.; Mataragas, M.; Pappa, E.; Badeka, A.V.; Bosnea, L. Innovative Intelligent Cheese Packaging with Whey Protein-Based Edible Films Containing Spirulina. Sustainability 2023, 15, 13909. https://doi.org/10.3390/su151813909
Kontogianni VG, Kosma I, Mataragas M, Pappa E, Badeka AV, Bosnea L. Innovative Intelligent Cheese Packaging with Whey Protein-Based Edible Films Containing Spirulina. Sustainability. 2023; 15(18):13909. https://doi.org/10.3390/su151813909
Chicago/Turabian StyleKontogianni, Vasiliki G., Ioanna Kosma, Marios Mataragas, Eleni Pappa, Anastasia V. Badeka, and Loulouda Bosnea. 2023. "Innovative Intelligent Cheese Packaging with Whey Protein-Based Edible Films Containing Spirulina" Sustainability 15, no. 18: 13909. https://doi.org/10.3390/su151813909
APA StyleKontogianni, V. G., Kosma, I., Mataragas, M., Pappa, E., Badeka, A. V., & Bosnea, L. (2023). Innovative Intelligent Cheese Packaging with Whey Protein-Based Edible Films Containing Spirulina. Sustainability, 15(18), 13909. https://doi.org/10.3390/su151813909

